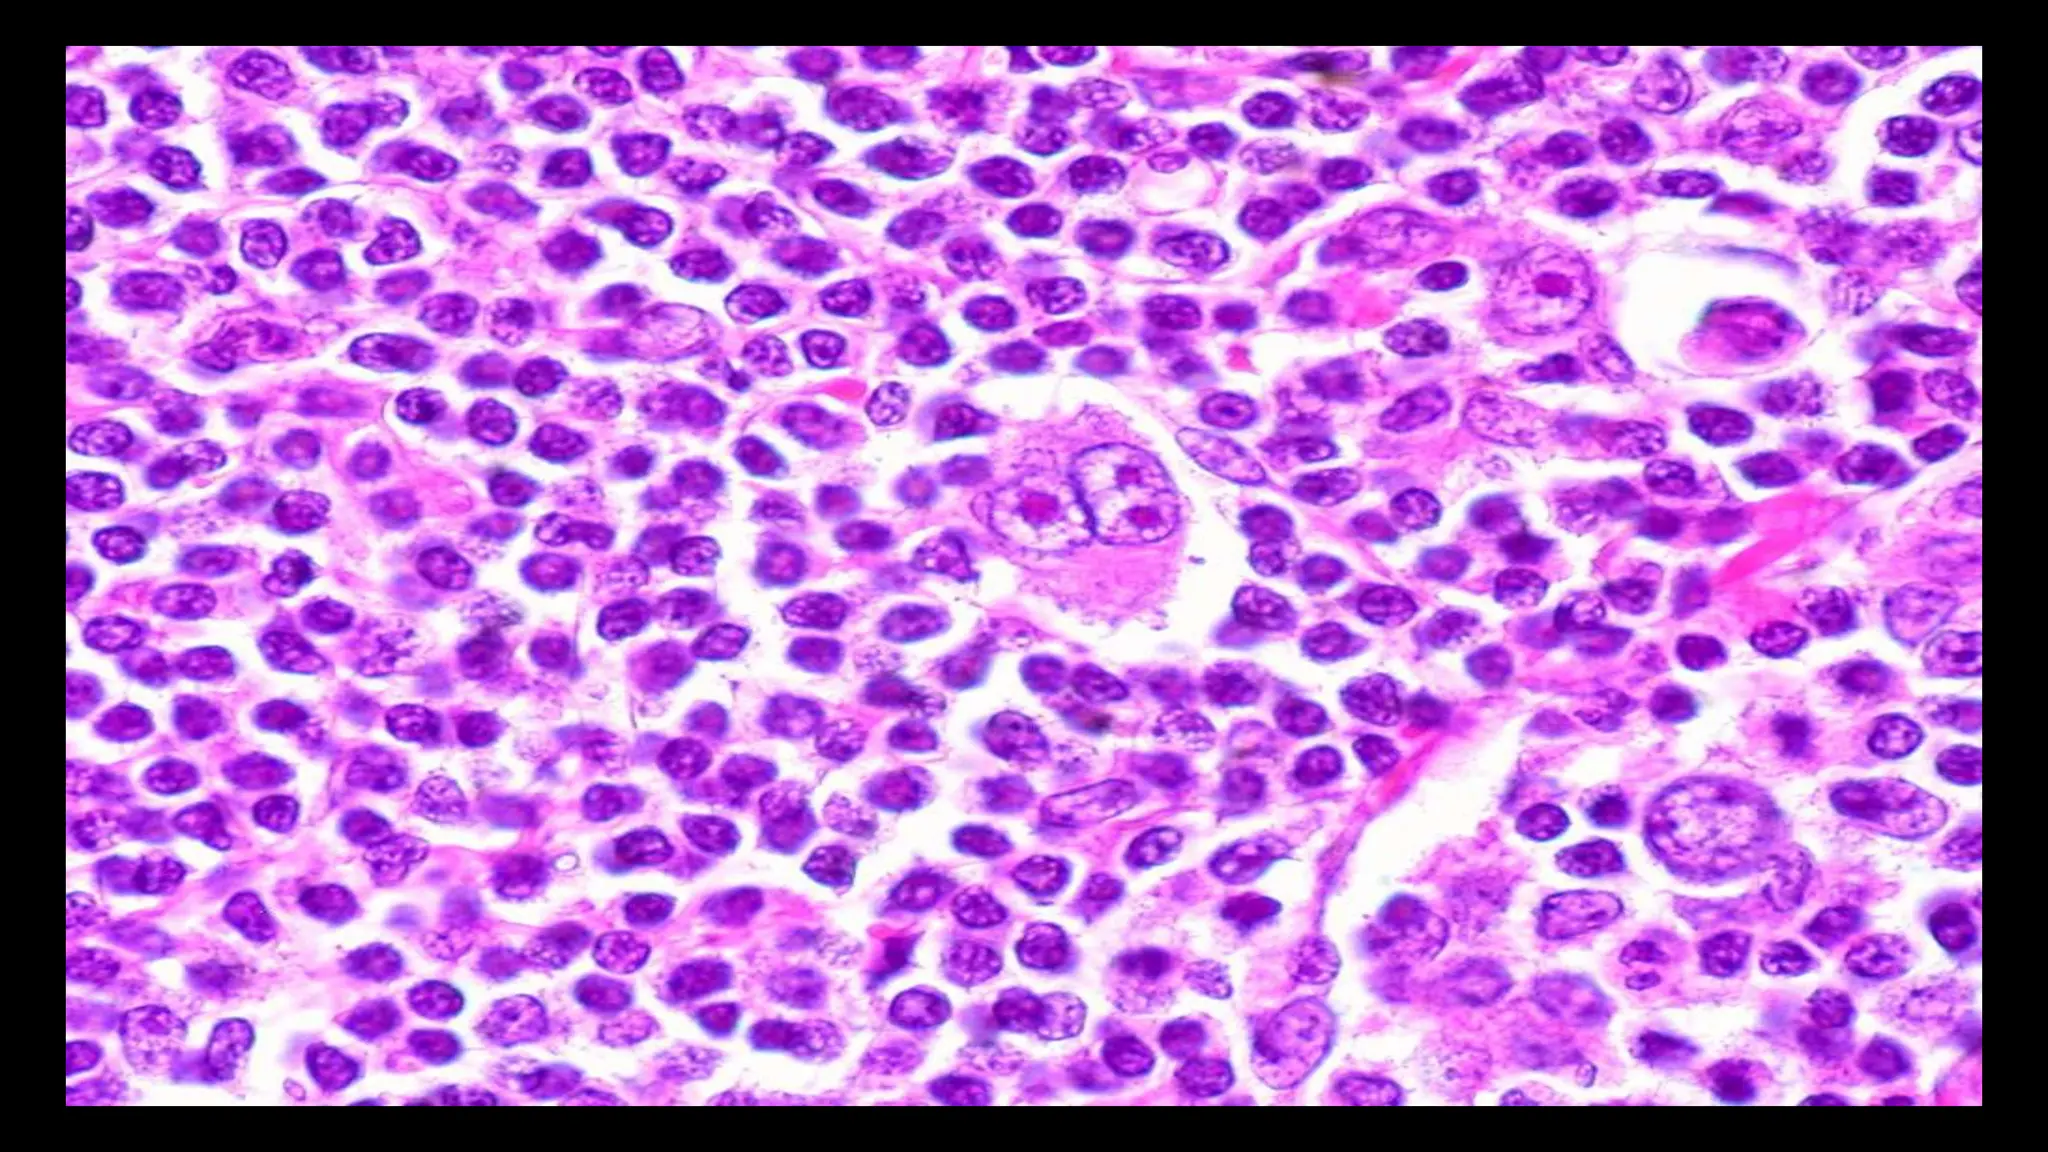

Lymphomas are cancers that originate from lymphocytes in the immune system, categorized into non-Hodgkin’s lymphoma (NHL) and Hodgkin’s lymphoma (HL). NHL is more common and involves various types of mature B and T cells, while HL is characterized by Reed-Sternberg cells, primarily starts in lymph nodes, and has more systemic involvement and characteristic symptoms. Effective treatments exist, with a majority of patients achieving remission, but late complications can include secondary cancers and cardiac issues.
![LYMPHOMAS
DR.AMRUTHA OLIVIA
MD GENERAL MEDICINE [PG-I]](https://image.slidesharecdn.com/lymphomasofolivia-copy-240725173053-530a72e8/75/Non-Hodgkins-Hodgkins-lymphoma-ppt-presentation-1-2048.jpg)
![DEFINITION OF LYMPHOMA
• Lymphoma is cancer that begins in infection-fighting cells of
the immune system, called LYMPHOCYTES. These cells are in
the lymph nodes, spleen, thymus, bone marrow, and other
parts of the body. When you have lymphoma, lymphocytes
change and grow out of control.
• There are two main types of lymphoma:
1)Non-Hodgkin’s lymphoma [NHL] – most common
2)Hodgkin’s lymphoma [HL]](https://image.slidesharecdn.com/lymphomasofolivia-copy-240725173053-530a72e8/75/Non-Hodgkins-Hodgkins-lymphoma-ppt-presentation-2-2048.jpg)

![DIFFERENCE BETWEEN NHL & HL
NON HODGKIN’S LYMPHOMA HODGKIN’S LYMPHOMA
• NHL are cancers of mature B, T, and natural killer
(NK) cells that can be classified as either a mature B-
NHL [80%] or a mature T/NK-NHL [20%] depending
on whether the cancerous lymphocyte is a B, T, or
NK cell respectively.
• Most of them start in a lymph node but still 1/3rd of
them are found in the extra lymphatic tissue.
• Systemic involvement is less common
• Even in early stages in most of the cases
radiotherapy combined with chemotherapy
treatment is needed
• HL is a malignancy of mature B lymphocytes
characterized by a heterogenous cellularity
comprising of minority of specific neoplastic
cells(Hodgkin's cells & Reed-Sternberg cells) in a
characteristic background of reactive non-neoplastic
cells of various types.
• Almost always starts in a lymph node.
• Systemic involvement is more common causing
symptoms such as fever, weight loss, night sweats
and pruritis.
• ~80–85% of patients will be cured of their
lymphoma by chemotherapy with or without
radiotherapy.](https://image.slidesharecdn.com/lymphomasofolivia-copy-240725173053-530a72e8/75/Non-Hodgkins-Hodgkins-lymphoma-ppt-presentation-4-2048.jpg)